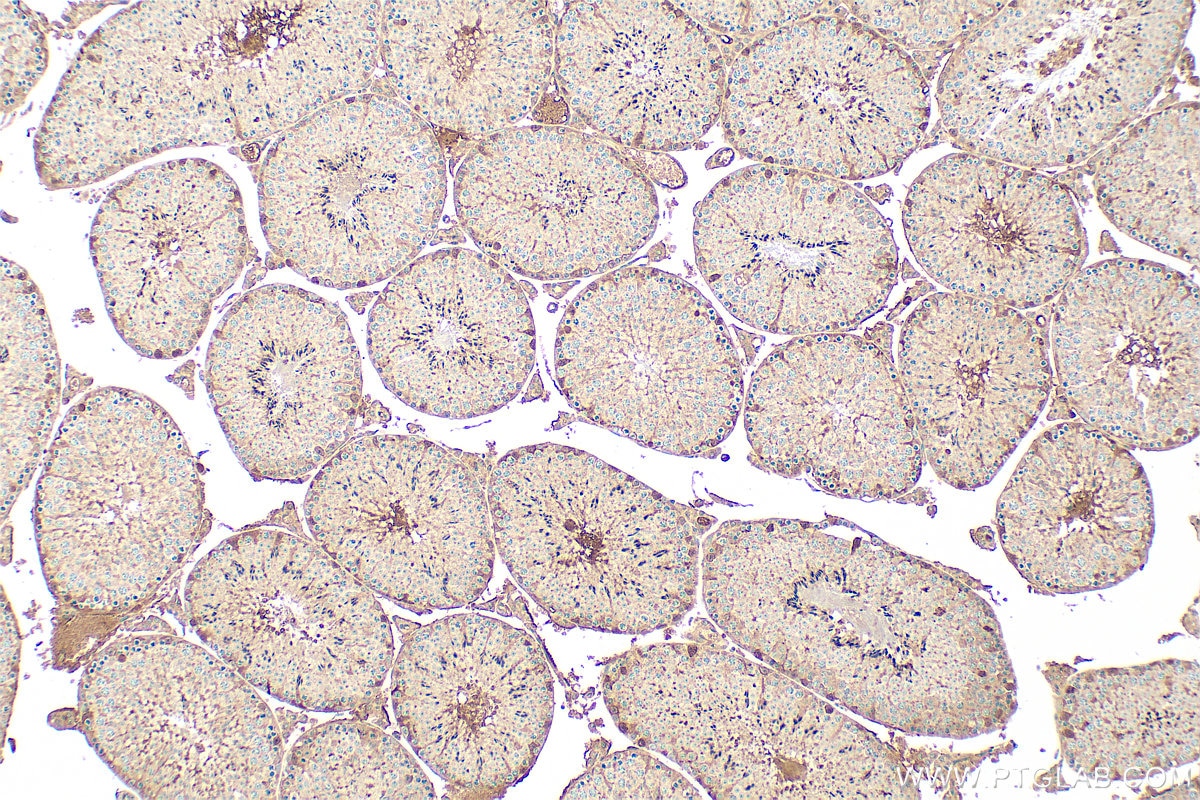
Immunohistochemistry (IHC) staining of mouse testis tissue using ARHGAP23 Polyclonal antibody (31938-1-AP)

Validation Data Gallery
Tested Applications
| Positive WB detected in | A549 cells, Calu-1 cells, HeLa cells |
| Positive IHC detected in | mouse testis tissue Note: suggested antigen retrieval with TE buffer pH 9.0; (*) Alternatively, antigen retrieval may be performed with citrate buffer pH 6.0 |
Recommended dilution
| Application | Dilution |
|---|---|
| Western Blot (WB) | WB : 1:1000-1:5000 |
| Immunohistochemistry (IHC) | IHC : 1:50-1:500 |
| It is recommended that this reagent should be titrated in each testing system to obtain optimal results. | |
| Sample-dependent, Check data in validation data gallery. | |
Product Information
31938-1-AP targets ARHGAP23 in WB, IHC, ELISA applications and shows reactivity with human, mouse samples.
| Tested Reactivity | human, mouse |
| Host / Isotype | Rabbit / IgG |
| Class | Polyclonal |
| Type | Antibody |
| Immunogen |
CatNo: Ag36340 Product name: Recombinant human ARHGAP23 protein Source: e coli.-derived, PET28a Tag: 6*His Domain: 500-700 aa of NM_001199417 Sequence: KVQLTPARQMNLGFGDESPEPEASGRGERLGRKVAPLATTEDSLASIPFIDEPTSPSIDLQAKHVPASAVVSSAMNSAPVLGTSPSSPTFTFTLGRHYSQDCSSIKAGRRSSYLLAITTERSKSCDDGLNTFRDEGRVLRRLPNRIPSLRMLRSFFTDGSLDSWGTSEDADAPSKRHSTSDLSDATFSDIRREGWLYYKQI 相同性解析による交差性が予測される生物種 |
| Full Name | Rho GTPase activating protein 23 |
| Calculated molecular weight | 162kDa |
| Observed molecular weight | 140-150 kDa |
| GenBank accession number | NM_001199417 |
| Gene Symbol | ARHGAP23 |
| Gene ID (NCBI) | 57636 |
| Conjugate | Unconjugated |
| Form | |
| Form | Liquid |
| Purification Method | Antigen affinity Purification |
| UNIPROT ID | Q9P227 |
| Storage Buffer | PBS with 0.02% sodium azide and 50% glycerol{{ptg:BufferTemp}}7.3 |
| Storage Conditions | Store at -20°C. Stable for one year after shipment. Aliquoting is unnecessary for -20oC storage. |
Background Information
ARHGAP23 (Rho GTPase Activating Protein 23) belongs to the family of Rho GTPase activating proteins. The protein functions as a GTPase-activating factor by converting Rho class GTPases into their inactive GDP-bound state. ARHGAP23 is involved in the Rho GTPase signaling pathway, affecting processes such as cytoskeletal reorganization, cell migration, and cell proliferation. In non-small cell lung cancer, the expression of ARHGAP23 is associated with tumor immune infiltration and prognosis, and its role in tumor development has attracted attention. Mutations in this gene are related to a variety of diseases, including certain types of cancer and neurological disorders.
Protocols
| Product Specific Protocols | |
|---|---|
| IHC protocol for ARHGAP23 antibody 31938-1-AP | Download protocol |
| WB protocol for ARHGAP23 antibody 31938-1-AP | Download protocol |
| Standard Protocols | |
|---|---|
| Click here to view our Standard Protocols |